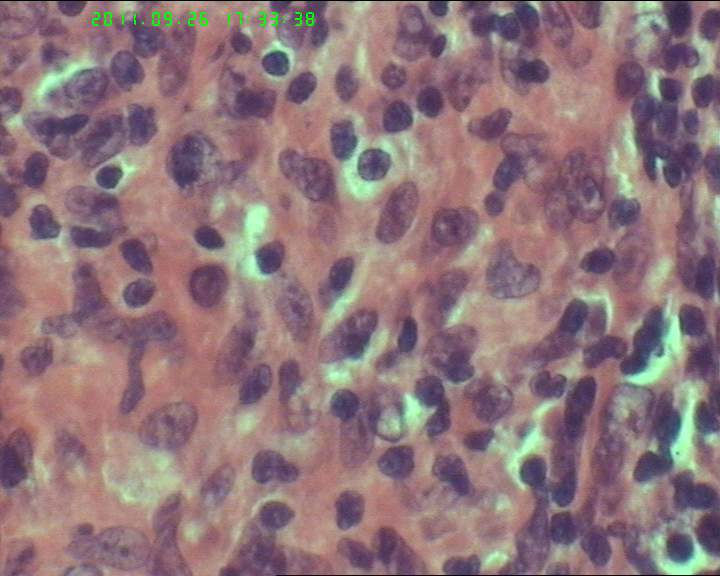
21岁女性左侧颌下淋巴结，该诊断什么？图19
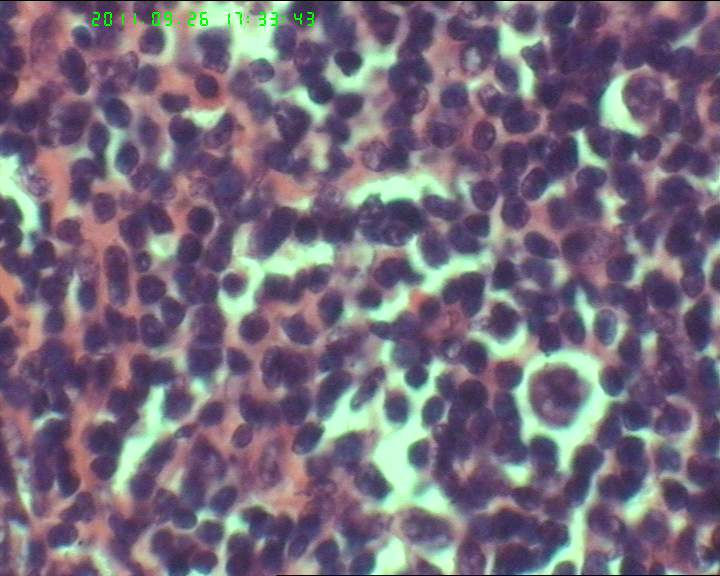
21岁女性左侧颌下淋巴结，该诊断什么？图20

| 图片: | |
|---|---|
| 名称: | |
| 描述: | |
- 21岁女性左侧颌下淋巴结,该诊断什么?
灰白不整形肿物一个,大小3.5*2.5*2cm,包膜完整。

名称:图1
描述:20110926-1.jpg.jpg

名称:图2
描述:20110926-2.jpg.jpg

名称:图3
描述:20110926-3.jpg.jpg

名称:图4
描述:20110926-4.jpg.jpg

名称:图5
描述:20110926-5.jpg.jpg

名称:图6
描述:20110926-6.jpg.jpg

名称:图7
描述:20110926-7.jpg.jpg

名称:图8
描述:20110926-8.jpg.jpg

名称:图9
描述:20110926-9.jpg.jpg

名称:图10
描述:20110926-10.jpg.jpg

名称:图11
描述:20110926-11.jpg.jpg

名称:图12
描述:20110926-14.jpg.jpg

名称:图13
描述:20110926-15.jpg.jpg

名称:图14
描述:20110926-16.jpg.jpg

名称:图15
描述:20110926-17.jpg.jpg

名称:图16
描述:20110926-18.jpg.jpg

名称:图17
描述:20110926-19.jpg.jpg

名称:图18
描述:20110926-20.jpg.jpg
名称:图19
描述:20110926-21.jpg.jpg
名称:图20
描述:20110926-22.jpg.jpg
标签:
×参考诊断























